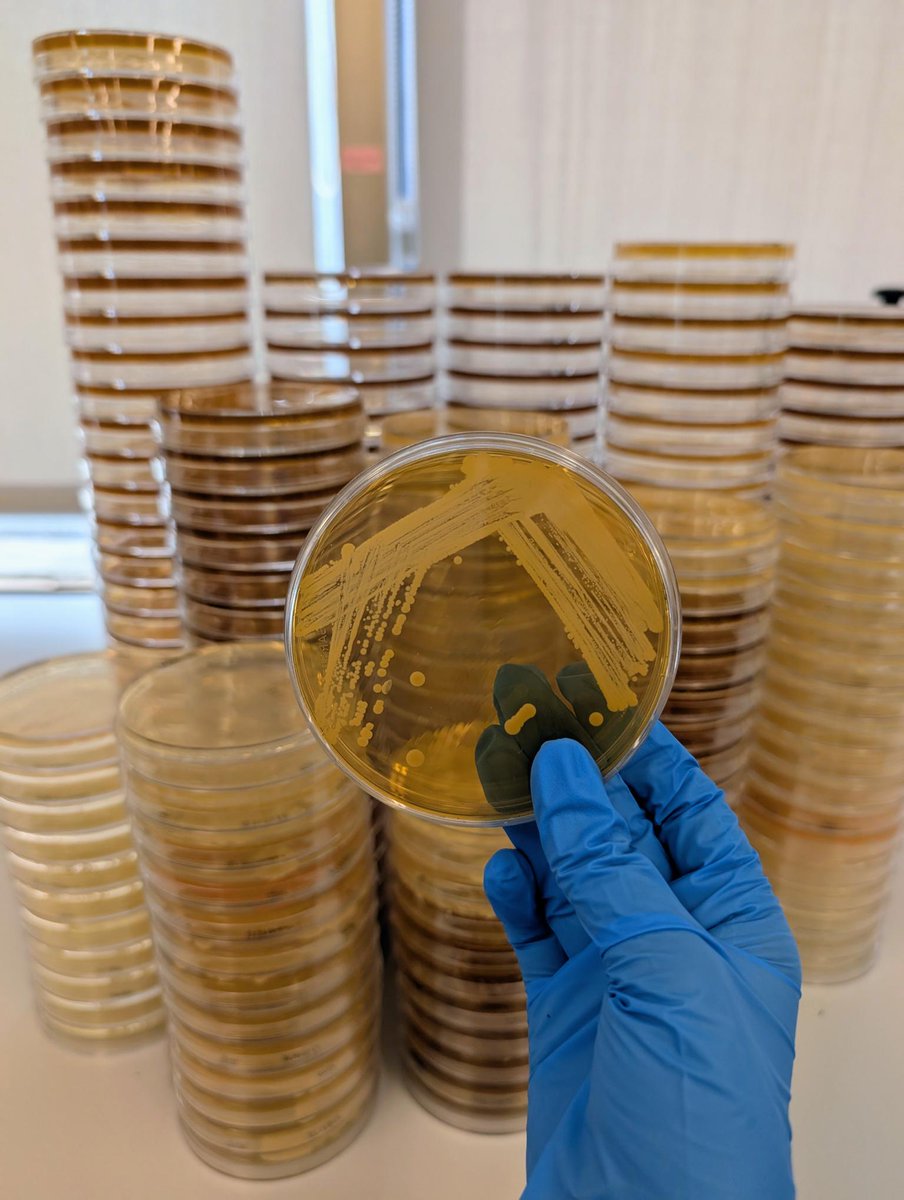
DarwinBioprosp's tweet image. @IntMicroDay 

On 17 September 1683, Antonie van Leeuwenhoek gave the world its very first glimpse of a single-celled organism — a discovery that forever changed science. Today, we celebrate microorganisms, the invisible allies that sustain life, ecosystems, and innovation.

International Microorganism Day
@IntMicroDay
Our goal is to raise world-wide awareness about the impact of microbes in all our lives | #InternationalMicroorganismDay | Email: [email protected]
Vous pourriez aimer
Bringing a science lab to a rural school. Raquel Branquinho shares how a project in Portugal gave students hands-on access to microbiology. The result: curiosity sparked, questions asked, and a new way of seeing the microbial world. 👉 Read more: buff.ly/jNOcfJp

It is nice to re-tweet this post. Happy @IntMicroDay 2025.
Really happy to be at the kick-off of this session on upcycling with extremomophiles: biotechnological advances for a sustainable future. Looking forward to the discussion. @FEMSmicro @cimab_uacam




Hoy 17 de septiembre se celebra también el Día Internacional del Microorganismo. Los microorganismos juegan roles esenciales en la salud humana, animal, de plantas y de ecosistemas, así como en el funcionamiento de la biosfera y en la productividad de los ecosistemas que inciden…
Éxito total en el #InternationalMicroorganismDay 🧫 @SEMicrobiologia @IntMicroDay



It's @IntMicroDay 2025! We celebrate the most common form of life on #Earth, whose presence we were blissfully unaware of until the latter half of the 17th century! Respect the #microbe 🦠🧫 #IMD2025

We celebrate @IntMicroDay tmr (Sep 18) @hood_college and on #Zoom with "Shot in the Arm". Come see the #film and ask questions of our panelists, including @dr_andrealove and @gorskon! Can't come in person? #Zoom invitation registration: tinyurl.com/mph-film-fest @frednewspost


It's @IntMicroDay 2025! We celebrate the most common form of life on #Earth, whose presence we were blissfully unaware of until the latter half of the 17th century! Respect the #microbe 🦠🧫 #IMD2025

On #InternationalMicroorganismDay , we at Culture Collections celebrate the vital role of microorganisms in sustaining life. Discover our work and get involved: culturecollections.org.uk @IntMicroDay #MicrobialScience #CultureCollections #ECACC #NCTC #NCPV #NCPF

🏆Celebrating the Grand Prize winner for #MicrobeArt2025 🏆 A huge congratulations to Matthias Frank at TU Dresden & Chris Hadfield for your unique submission. The composite image, merging a Bacillus subtilis biofilm with a night shot of Berlin.

A huge congratulations to 🎉 @joanacbarbosa 🏆, the winner of the #MicrobeArt2025 Best Poetry award✨ Her heartfelt poem 💖 is a powerful tribute to the unseen beauty 🌿🔬 and importance of microbes, truly celebrating the microbial world 🌎🦠. #InternationalMicroorganismDay

It’s International Microorganism Day! We asked the Society’s Champions to tell us about their favourite microbes and, our Champion, Eliza Wolfson, has created some fun illustrations to show you a bit more of their character! @eliza_coli @FEMSmicro #InternationalMicroorganismDay




The winner of the #MicrobeArt2025 competition for Best Physical Piece is Forouzan Shafie. Your stunning piece, "Invisible Artists," beautifully connects the ancient art of Persian carpet weaving with the unseen world of microbes. An incredible tribute to the "invisible artists".

Congratulations to Matthias Frank at TU Dresden and Chris Hadfield , the winner of the #MicrobeArt2025 competition for Best Photography 📸 Your incredible composite image of a Bacillus subtilis biofilm and Berlin at night perfectly bridges art and science. Well Done!

Congratulations to Malia Miguel, the winner of the #MicrobeArt2025 competition for Best Painting🎨 Your acrylic piece, "Biomorph I," beautifully captures the dynamic movement and surreal world of microbes. A truly artistic masterpiece. #InternationalMicroorganismDay

@IntMicroDay On 17 September 1683, Antonie van Leeuwenhoek gave the world its very first glimpse of a single-celled organism — a discovery that forever changed science. Today, we celebrate microorganisms, the invisible allies that sustain life, ecosystems, and innovation.
For #InternationalMicroorganismDay, we asked our FEMS MICRO 2025 Keynote Speakers and FEMS Journal Editors "'What is your favourite microbe?'' With delightful answers this was the perfect way to celebrate IMD 2025! youtu.be/oEJsWNJCtBw

youtube.com
YouTube
Favourite Microbes for International Microorganism Day 2025
And the winner for Best Cartoon in the #MicrobeArt2025 competition is... Deyn 🏆 Your submission captures a serious issue—the rapid evolution of AMR in microbes. A perfect blend of scientific insight and witty commentary. Well done! #InternationalMicroorganismDay

Congratulations to @lau_boratorio, the winner of the #MicrobeArt2025 Agar Art category🏆 Your "Lilo & Stitch" piece, created with microbes, perfectly captures the spirit of 'ohana and art. We love the detail and creativity. Mahalo for sharing! #InternationalMicroorganismDay

Keep Calm and... Happy #internationalmicroorganismday!!! @SEMicrobiologia @FEMSmicro @IntMicroDay

Ideales esos cocos grampositivos. Feliz #InternationalMicroorganismDay
Mañana celebramos el @IntMicroDay 🧫 ! No faltes ! Estaremos en el Hall de la Facultad de Farmacia ! @SEMicrobiologia #microorganisms. Y llévate tu Gram-pin




Hoy es el #DiaInternacionalMicroorganismos #InternationalMicroorganismDay Desde la SEM iremos difundiendo las diferentes actividades. ¡Todo por la micro!

United States Tendances
- 1. Peggy 32.3K posts
- 2. Sonic 06 2,444 posts
- 3. Berseria 4,883 posts
- 4. Zeraora 14.9K posts
- 5. Cory Mills 30.1K posts
- 6. #ComunaONada 3,509 posts
- 7. $NVDA 44.7K posts
- 8. Randy Jones N/A
- 9. Dearborn 379K posts
- 10. Cooks 10.1K posts
- 11. Ryan Wedding 4,445 posts
- 12. #Stargate N/A
- 13. Rick Hendrick 1,180 posts
- 14. International Men's Day 85.1K posts
- 15. Saudi Investment Forum 3,738 posts
- 16. Luxray 2,467 posts
- 17. #CurrysPurpleFriday 13.6K posts
- 18. Encyclopedia Galactica 6,068 posts
- 19. Ronaldo 257K posts
- 20. #wednesdaymotivation 8,232 posts
Vous pourriez aimer
-
 FEMS
FEMS
@FEMSmicro -
 ISME - International Society for Microbial Ecology
ISME - International Society for Microbial Ecology
@ISME_microbes -
 Contamination Club
Contamination Club
@ContamClub -
 bioRxiv Microbiology
bioRxiv Microbiology
@biorxiv_micrbio -
 Microbiology Society
Microbiology Society
@MicrobioSoc -
 BacterialWorld
BacterialWorld
@Bacterialworld -
 Nature Microbiology
Nature Microbiology
@NatureMicrobiol -
 Trends in Microbiology
Trends in Microbiology
@TrendsMicrobiol -
 AppEnvMicro journal
AppEnvMicro journal
@AppEnvMicro -
 mBio
mBio
@mbiojournal -
 National Biofilms Innovation Centre (NBIC)
National Biofilms Innovation Centre (NBIC)
@ukbiofilms -
 Frontiers - Microbiology
Frontiers - Microbiology
@FrontMicrobiol -
 Applied Microbiology International
Applied Microbiology International
@AMIposts -
 ASM Newsroom
ASM Newsroom
@ASMnewsroom -
 Akos T. Kovacs
Akos T. Kovacs
@EvolvedBiofilm
Something went wrong.
Something went wrong.










































































































































